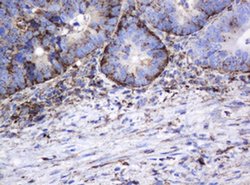
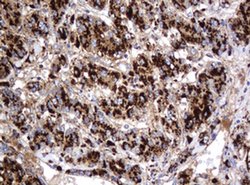
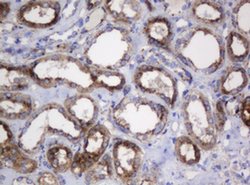
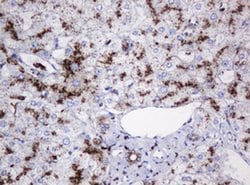

Promotional price valid on web orders only. Your contract pricing may differ. Interested in signing up for a dedicated account number?
Learn More
Learn More
Invitrogen™ GLB1 Monoclonal Antibody (OTI1C9)


Mouse Monoclonal Antibody
Supplier: Invitrogen™ MA526152
Description
GLB1 Monoclonal Antibody for Western Blot, IHC (P)
Beta Galactosidase encodes a member of the glycosyl hydrolase 35 family of proteins. Alternative splicing results in multiple transcript variants, at least one of which encodes a preproprotein that is proteolytically processed to generate the mature lysosomal enzyme. This enzyme catalyzes the hydrolysis of a terminal beta-linked galactose residue from ganglioside substrates and other glycoconjugates. Mutations in this gene have been associated with GM1-gangliosidosis and Morquio B syndrome. Diseases associated with GLB1 include Gm1-Gangliosidosis, Type I and Gm1-Gangliosidosis, Type Ii.
Specifications
| GLB1 | |
| Monoclonal | |
| 1 mg/mL | |
| PBS with 1% BSA, 50% glycerol and 0.02% sodium azide; pH 7.3 | |
| P16278, Q9TRY9 | |
| GLB1 | |
| Full length human recombinant protein of GLB1 produced in HEK293T cell. | |
| 100 μL | |
| Primary | |
| Human, Canine, Monkey | |
| Antibody | |
| IgG2a |
| Immunohistochemistry (Paraffin), Western Blot | |
| OTI1C9 | |
| Unconjugated | |
| GLB1 | |
| acid beta-galactosidase; AW125515; betagal; Beta-Gal; Beta-galactosidase; bgal; Bge; Bgl; Bgl-e; Bgl-s; Bgl-t; Bgs; Bgt; C130097A14Rik; EBP; Elastin receptor 1; elastin receptor 1, 67kDa; ELNR1; galactosidase beta 1; galactosidase, beta 1; GLB1; Glb-1; lactase; lysosmal hydrolase; lysosomal beta-galactosidase; lysosomal hydrolase; MPS4B; ßgal; ß-gal; ß-galactosidase | |
| Mouse | |
| Affinity chromatography | |
| RUO | |
| 2720, 403873 | |
| -20°C, Avoid Freeze/Thaw Cycles | |
| Liquid |
Product Content Correction
Your input is important to us. Please complete this form to provide feedback related to the content on this product.
Product Title
Spot an opportunity for improvement?Share a Content Correction